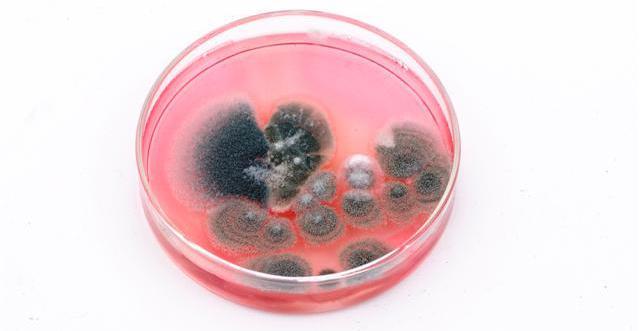
Descubrimiento de la Penicilina.

-
Se dice que los mayas descubreron el 0, pero no supieron darle la utilidad que tiene ahora.
-
Los primeros homínidos utilizaban el fuego para calentarse,
asar alimentos, endurecer los utensilios, prolongar las horas
de luz, asustar a los animales, cocer la arcilla y organizar los
primeros campamentos, incluso en áreas de frío intenso. -
Los signos cuneiformes eran escritos por escribas usando cuñas principalmente sobre tablillas, casi siempre de arcilla y ocasionalmente de metal, que luego se guardaban en una suerte de primitivas bibliotecas. Servían para el aprendizaje de futuros escribas. Estas bibliotecas pertenecían a la escuela de cada ciudad o, a veces, a colecciones particulares.
-
El alfabeto griego es un alfabeto de veinticuatro letras utilizado para escribir la lengua griega. A partir del alfabeto consonántico fenicio, los griegos adoptaron el primer alfabeto completo de la historia, entendiéndolo como la escritura que expresa los sonidos individuales del idioma, es decir que prácticamente a cada vocal y cada consonante corresponde un símbolo distinto.
-
Es una universidad pública italiana situada en la ciudad de Bolonia. Fue fundada en 1088 como una agrupación de estudiantes por Irnerio partiendo de las escuelas municipales y adquiriendo el grado de Universidad.
Es la universidad más antigua del mundo occidental y está entre las grandes universidades europeas como las de Oxford, París o Salamanca, creadas a propósito de su ejemplo. -
La imprenta es un método mecánico destinado a reproducir textos e imágenes sobre papel, tela u otros materiales.
-
El primer periódico impreso conocido se llama Strassburger Relation, y apareció precisamente en Estrasburgo.
-
-
La historia de la fotografía empieza oficialmente en el año 1839, con la divulgación mundial del primer procedimiento fotográfico: el daguerrotipo.
Como antecedentes de la fotografía, se encuentran la cámara oscura y las investigaciones sobre las sustancias fotosensibles, especialmente el ennegrecimiento de las sales de plata. -
El telégrafo es un dispositivo que utiliza señales eléctricas para la transmisión de mensajes de texto codificados, como con el código Morse, mediante líneas alámbricas o radiales.
-
El teléfono es un dispositivo de telecomunicación diseñado para transmitir señales acústicas a distancia por medio de señales eléctricas.
Durante mucho tiempo Alexander Graham Bell fue considerado el inventor del teléfono, junto con Elisha Gray. Sin embargo, Bell no fue el inventor de este aparato, sino solamente el primero en patentarlo. -
Paul Gottlieb Nipkow inventó y patentó un elemento explorador de la imagen formado por un disco metálico perforado por unos agujeros cuadrangulares colocados en espiral que bautizó con el nombre de disco de Nipkow.
-
Un cinematógrafo es una máquina capaz de filmar y proyectar imágenes en movimiento. Fue la primera máquina capaz de rodar y proyectar películas de cine.
-
Las primeras emisiones públicas de televisión las efectuó la BBC en Inglaterra en 1927 y la CBS y NBC en Estados Unidos en 1930. En ambos casos se utilizaron sistemas mecánicos y los programas no se emitían con un horario regular.
-
La descubrió Alexander Fleming por error. En uno de sus cultivos crecio un hongo (la penicilina es un hongo) y se dio cuenta que a su alrededor no se desarrollaba ninguna bacteria.
La Penicilina se descubrió, no se inventó, digo esto porque hay gente que piensa que se inventó. -
El Z1 está considerado como el primer computador mecánico programable del mundo.
-
Apolo 11 fue una misión espacial tripulada de Estados Unidos cuyo objetivo fue lograr que un ser humano caminara en la superficie de la Luna. La misión se envió al espacio el 16 de julio de 1969, llegó a la superficie de la Luna el 20 de julio de ese mismo año y al día siguiente logró que 2 astronautas (Armstrong y Aldrin) caminaran sobre la superficie lunar.
-
El disco compacto es una evolución tecnológica del LaserDisc. Los prototipos fueron desarrollados por Philips y Sony, primero de manera independiente y posteriormente de manera conjunta. Fue presentado en junio de 1980 a la industria, y se adhirieron al nuevo producto 40 compañías de todo el mundo mediante la obtención de las licencias correspondientes para la producción de reproductores y discos.
-
-
Conjunto de redes de ordenadores creada a partir de redes de menos tamaño, cuyo origen reside en la cooperación de dos universidades estadounidenses.
Looking for a timeline maker?
Create timelines for projects, roadmaps, history, lessons, legal cases, and stories with Timetoast. Timetoast is a timeline maker for work, school, research, and stories.